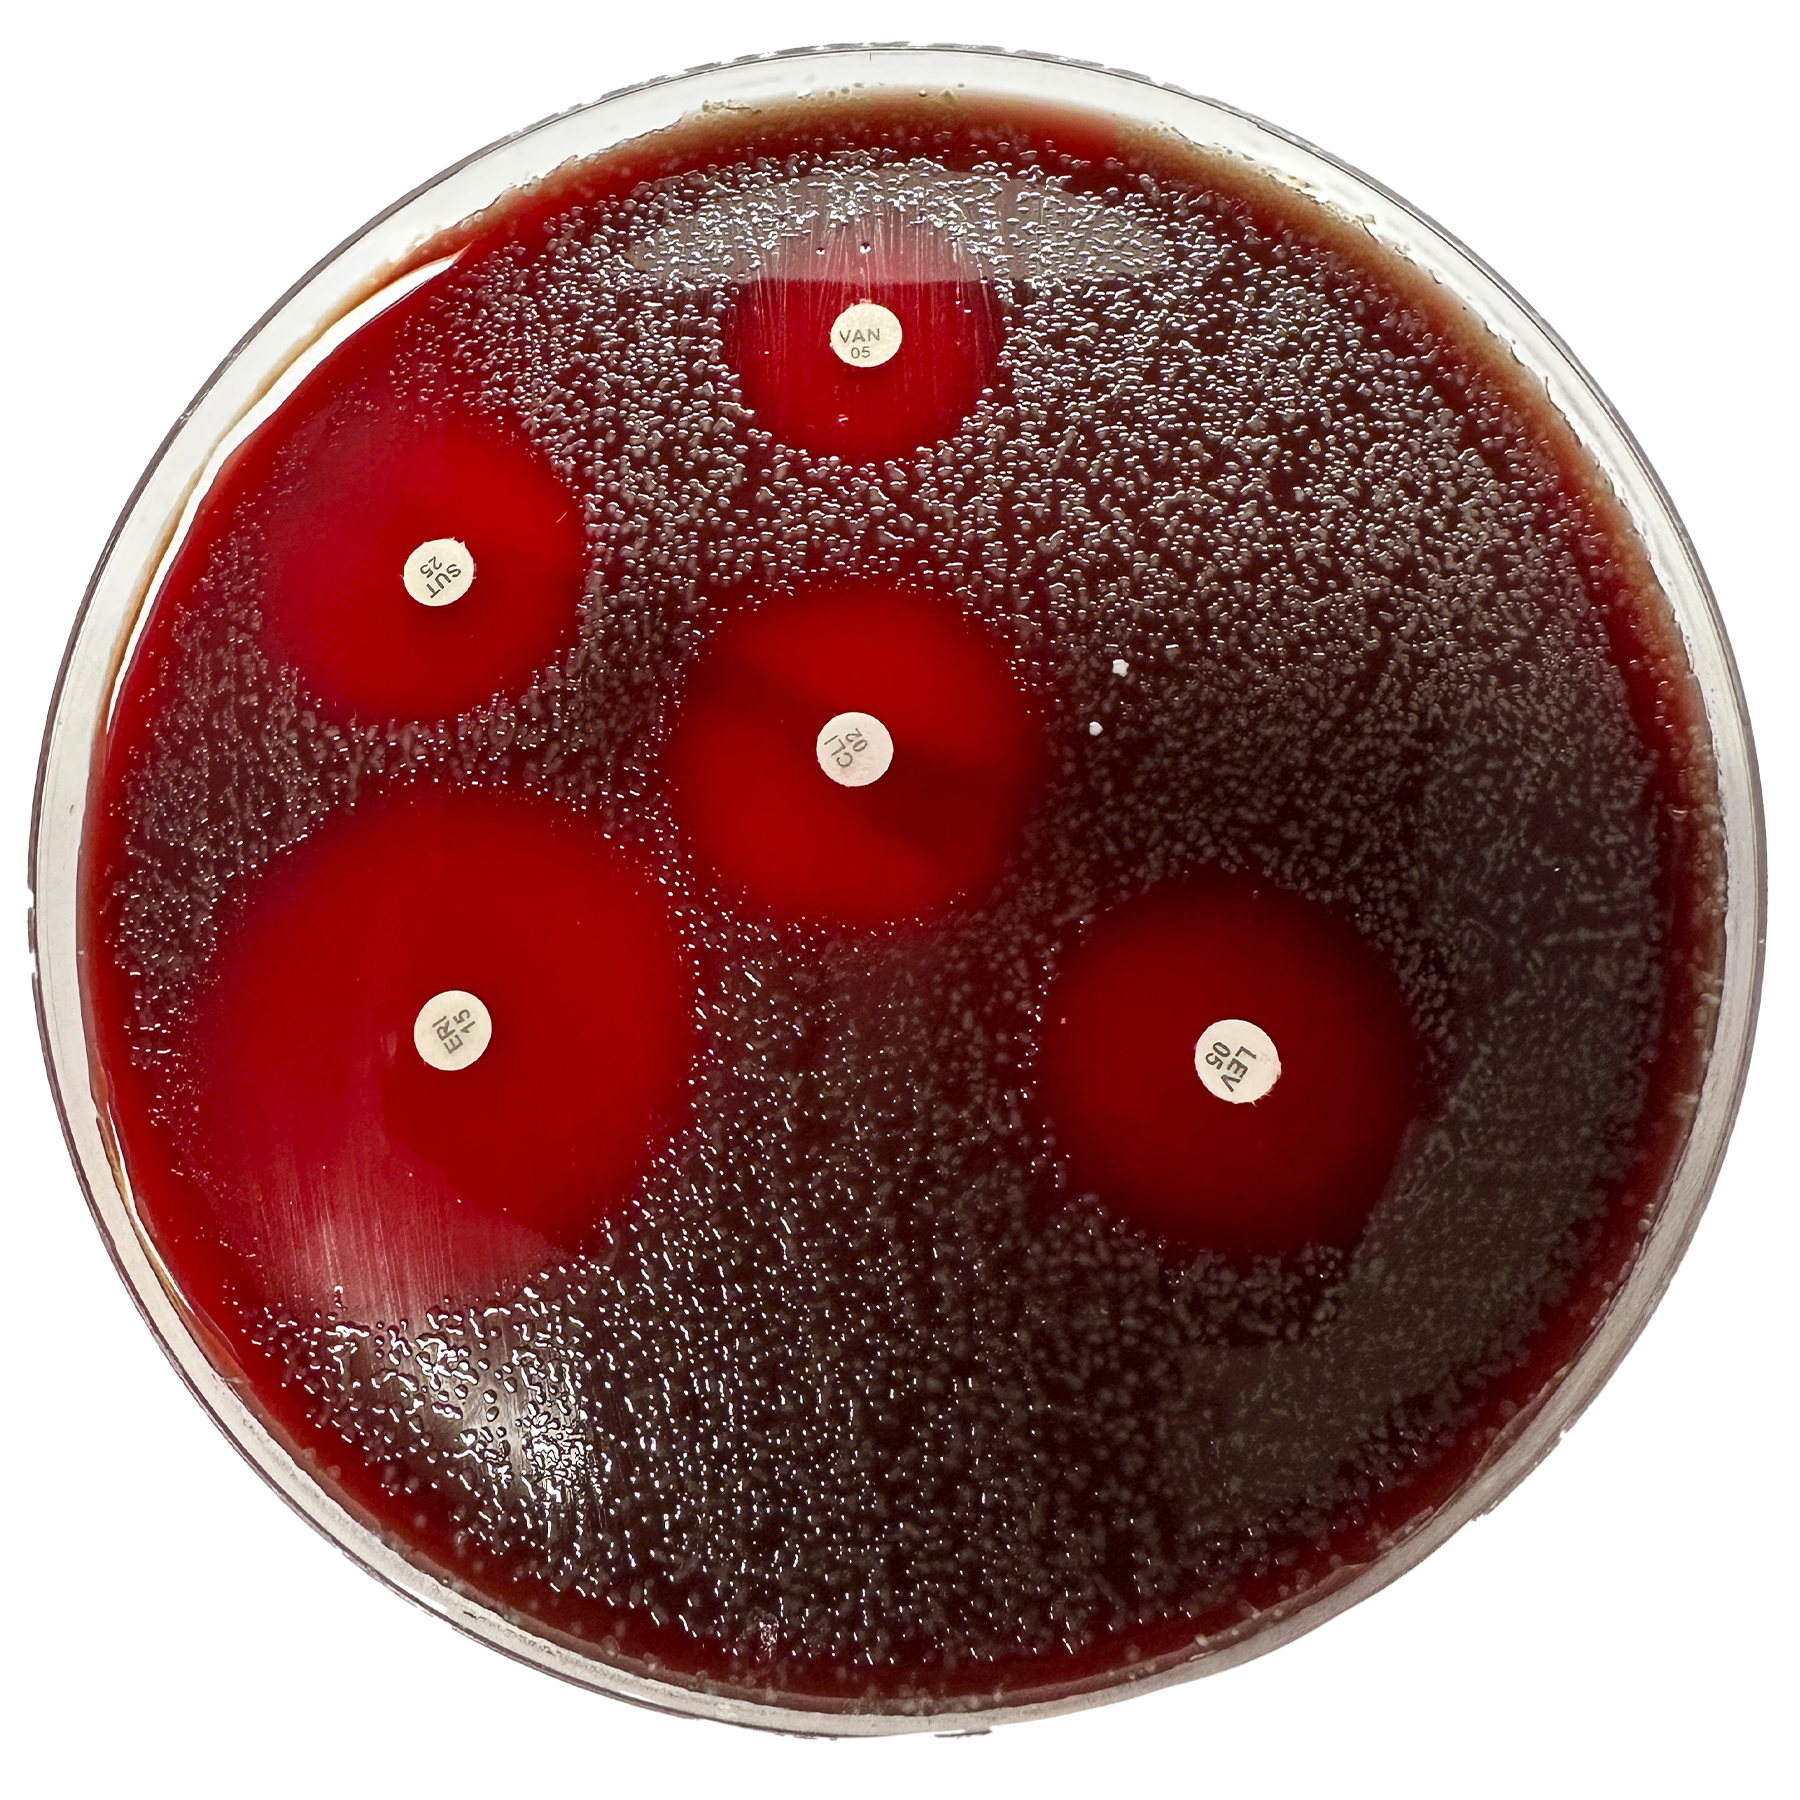

1
/
de
1
Renylab
Ágar Mueller Hinton + Sangue – 10 Placas (140 × 15 mm)
Ágar Mueller Hinton + Sangue – 10 Placas (140 × 15 mm)
Preço normal
R$ 127,74 BRL
Preço normal
R$ 159,67 BRL
Preço promocional
R$ 127,74 BRL
Frete calculado no checkout.
Calcule o Frete
Quantidade
Não foi possível carregar a disponibilidade de retirada.
Ágar Mueller Hinton + Sangue – 10 Placas (140 × 15 mm)
Descrição
O Ágar Mueller Hinton com Sangue é um meio de cultura nutritivo e enriquecido, amplamente utilizado para a realização de antibiogramas pela técnica de difusão (discos de Kirby-Bauer) e para o cultivo de microrganismos exigentes.
A adição de 5% de sangue desfibrinado fornece nutrientes adicionais e permite a observação de reações hemolíticas, garantindo resultados precisos e confiáveis nos testes de sensibilidade a antimicrobianos.
Características Técnicas
-
Apresentação: pacote com 10 placas (140 × 15 mm)
-
Tipo de meio: nutritivo e enriquecido
-
Aplicação: antibiograma e cultivo de microrganismos fastidiosos
-
Composição: base Mueller Hinton suplementada com 5% de sangue desfibrinado
-
Validade: 3 meses a partir da data de fabricação
-
Armazenamento: 2–8 °C, protegido da luz
Registro ANVISA: 80002670074
Share